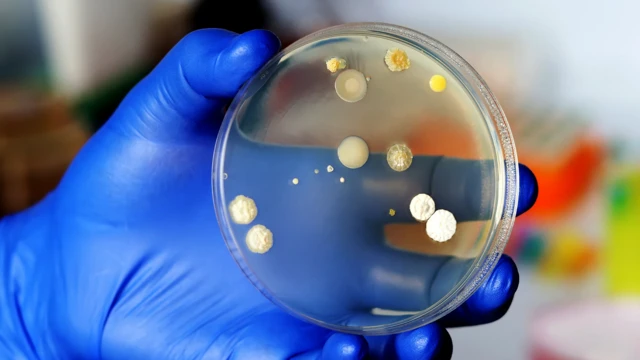
සෙල්සියස් අංශක 50ක (122F) උෂ්ණත්වයක් දක්වා දිලීරවලට නොනැසී පැවතිය හැකියි

නිතර ඔබේ ඇඳ ඇතිරිලි මාරු කළ යුත්තේ ඇයි?

ඡායාරූප මූලාශ්රය, Getty Images
- Author, ජැස්මින් ෆොක්ස්-ස්කෙලී
- Role, බීබීසී ෆියුචර්
අපගේ දෛනික ජීවිතයෙන් තුනෙන් එකක් අපි ගත කරන්නේ අපගේ ඇඳ ඇතිරිලි සහ කොට්ට සමග වන අතර, එම සියලු ස්පර්ශයන් සියලු ම ආකාරයේ අනවශ්ය අමුත්තන්ට පරිපූර්ණ පරිසරයක් සකසා දෙයි.
දීර්ඝ දිනයකට පසු, මෘදු කොට්ටයක ඔබේ හිස තබාගෙන මෘදු ඝන ඇතිරිල්ලක ඔබව ඔතාගෙන උණුසුම් ඇඳක වැතිරීම වැනි හැඟීමක් තරම් අන් දෙයක් නොමැත. කෙසේ වෙතත් ඇඳක වැතිර සිටීමේ ප්රීතියක් දැනෙන්නේ මිනිසුන් වන අපට පමණක් නොවේ.
මතුපිටට ඔබ්බෙන් බැලූ විට, ඔබේ ඇඳ ඇතිරිල්ල බැක්ටීරියා, දිලීර, මයිටාවන් සහ වෛරස් මිලියන ගණනකට ආගන්තුක සත්කාර සපයන බව දැනගත් විට ඔබ බියට පත් වන්නට පුළුවන. එම සියලු ආගන්තුකයින් ද සිතන්නේ ඔබේ ඇඳ ඔවුන්ට වර්ධනය විය හැකි දහඩියෙන්, කෙළවලින්, මියගිය සමේ සෛලවලින් සහ ආහාර අංශුවලින් පිරී ඇති ස්වර්ගයක් බව ය.
දූවිලි මයිටාවෙකු ගැන සිතන්න. ඔබ කුඩා දූවිලි මයිටාවෙකු නම් හැම දෙයක් ම ආහාරයක් විදිහට කෑ හැකි සමේ සෛල මිලියන 500ක් අප විසින් දිනක දී ඉවත ලනු ලබයි. නමුත් අවාසනාවන්ත ලෙස කෘමීන් සහ ඔවුන්ගේ මළපහ යන දෙවර්ගය ම ආසාත්මිකතා, ඇදුම සහ පණු රෝග ඇති කරයි.
ඇඳ ඇතිරිලි බැක්ටීරියාවලට ද ක්ෂේම භූමියකි. නිදසුනක් වශයෙන් 2013 දී ප්රංශයේ පාස්චර් ඩි ලිල්ලා ආයතනයේ පර්යේෂකයන් විසින් රෝහලේ රෝගීන්ගේ ඇඳ ඇතිරිලි විශ්ලේෂණය කිරීමේදී සොයා ගනු ලැබුවේ, කිළිටි ඇතිරිලි මිනිස් හමේ සාමාන්යයෙන් සොයාගත හැකි බැක්ටීරියාවක් වන Staphylococcus බැක්ටීරියාවලින් පිරී ඇති බව ය. බොහෝ Staphylococcus කුලයන් මෘදු වුවත් S. aureus වැනි සමහරක් සමේ ආසාදන, කුරුලෑ ඇති කරන අතර, නියුමෝනියා රෝගීන්ගේ ප්රතිශක්තිකරණ පද්ධතිය දුර්වල කිරීමට පවා හේතු විය හැකි ය.
"මිනිස්සු ඔවුන්ගේ ශරීර සමේ ක්ෂුද්ර ජීවීන්ගේ කොටසක් විදිහට බැක්ටීරියා අරගෙන යනවා සහ ඒවා ලොකු ගණනකින් ඉවත දාන්නත් පුළුවන්," අධ්යයනයට සහභාගී නොවූ එක්සත් රාජධානියේ වෙස්ට්මිනිස්ටර් විශ්වවිද්යාලයේ ක්ෂුද්ර ජීව විද්යාඥයෙකු වන මනල් මොහොමඩ් පවසයි.

ඡායාරූප මූලාශ්රය, Getty Images
"සාමාන්යයෙන් මෙම බැක්ටීරියා හානිදායක නොවුව ද, රෝහල්වල නිතර ම දකින්න පුළුවන් විවෘත තුවාල මගින් ඒවා ශරීරයට ඇතුළු වුණොත් ඒවා බරපතළ රෝග තත්ත්වයන්ට හේතු වෙන්න පුළුවන්," මොහොමඩ් පවසයි.
සනීපාරක්ෂාව වැදගත් ලෙස සලකන හෙයින් සහ රෝගීන් අතර ඇඳ ඇතිරිලි සහ කොට්ට සේදීම සිදු කරන හෙයින් රෝහල් යනු දත්ත සඳහා හොඳ මූලාශ්රයකි. 2018 දී නයිජීරියාවේ ඉබදාන් විශ්වවිද්යාලයේ විද්යාඥයන් පිරිසක් සොයා ගත්තේ රෝහලේ නොසේදූ ඇඳ ඇතිරිලිවල මුත්රා ආසාදන, නියුමෝනියාව, පාචනය, මොළේ උණ, ලේ විෂවීමට හේතු වන වෙනත් ව්යාධිජනක බැක්ටීරියාවන් සමග E. coli ද තිබෙන බව ය.
උණුසුම් පුවත්, විශ්ලේෂණ සහ විශේෂ විශේෂාංග ඔබේ දුරකතනය වෙත ඍජුව ම ලබා ගන්න.
සම්බන්ධ වීමට link එක click කරන්න
End of podcast promotion
අපිරිසිදු ලිනන් [රෙදි වර්ගයක්] එවැනි තත්ත්වයක් තුළ සැබෑ ආසාදන අවදාමක් නියෝජනය කරයි. 2022 දී පර්යේෂකයන් විසින් මන්කිපොක්ස් (දැන් mpox ලෙස හඳුන්වන) රෝගයෙන් රෝහල්ගත වූ රෝගීන්ගේ කාමරවලින් සාම්පල එකතු කර ගන්නා ලදී. ඔවුන් සොයා ගත්තේ, ඇඳ ඇතිරිලි මාරු කිරීමේ ක්රියාවේදී වෛරසය ව්යාප්ත විය හැකි අංශු වාතයට එක්වන බව ය. 2018 දී එක්සත් රාජධානියේ සෞඛ්ය සේවකයෙකු විශ්වාස කළේ, රෝගියෙකුගේ ඇඳ ඇතිරිලි වෙනස් කිරීමේදී වෛරසයට නිරාවරණය වීම නිසා රෝගය උත්සන්න වූ බව ය.
දියුණු රටවල්වල අවම වශයෙන් සම්ප්රේෂණය සීමා කිරීමට රෝහල්වලට දැඩි ක්රියාපටිපාටි පැනවීමට සිදුවිය.
"සෞඛ්ය සම්පන්න පුද්ගලයින්ගේ ඇඳ ඇතිරිලිවලට වඩා රෝහල්වල රෝගීන් නිදා සිටි ලිනන් රෙදිවල ව්යාධිජනක බැක්ටීරියා සොයා ගැනීමට වැඩි හැකියාවක් තිබේ."
“රෝහල්වල රෙදි ඔවුන් සෝදන්නේ බැක්ටීරියා වැඩි ප්රමාණයක් විනාශ කරන දැඩි උෂ්ණත්වයක් යටතේ," එක්සත් රාජධානියේ මැන්චෙස්ටර් විශ්වවිද්යාලයේ බෝවන රෝග සහ ගෝලීය සෞඛ්ය පිළිබඳ මහාචාර්ය ඩේවිඩ් ඩෙනින් පවසයි.
විශේෂයෙන් ම වයස්ගත පුද්ගලයන්ට පාචනය ඇති කරන C. difficile බැක්ටීරියාව සුවිශේෂී වේ. ඩෙනින්ට අනුව ඇතිරිලි සේදීමෙන් C. difficile බැක්ටීරියා අඩක් ම විනාශ කළ හැකි වුවත්, බීජාණු විනාශ කිරීමට අපහසු ය. එසේ වුවත්, එක්සත් රාජධානිය තුළ C. difficile ආසාදන අනුපාතය අඩු වීම යෝජනා කරන්නේ, ඔවුන් සම්මත රෝහල් රෙදි සේදීමේ ක්රියාපටිපාටීන් අනුගමනය කරන තාක් කල් බැක්ටීරියා, වෛරස් සම්ප්රේෂණය වීමේ අවදානම ඉතා අඩු මට්ටමක පවත්වා ගැනීමට හැකි බව ය.
ඇත්ත වශයෙන් ම, සෞඛ්ය සම්පන්න පුද්ගලයින්ගේ ඇඳ ඇතිරිලිවලට වඩා ඔබට රෝහල්වල රෝගීන් නිදා සිටි රෙදිවල ව්යාධිජනක බැක්ටීරියා සොයා ගැනීමට වැඩි හැකියාවක් තිබේ. නමුත් ඔබේ නිවසේ ඇති කැපී පෙනීමක් නැති ඇඳ ඇතිරිලි සහ කොට්ට ගැන කීමට හැකි කුමක් ද? 2013 දී, ඇමෙරිකානු ඇඳන් [විකිණීමේ] සමාගමක් වන Amerisleep ප්රකාශ කළේ සතියකින් නොසෝදා තිබූ කොට්ට උරයකින් ඔවුන් පැල්ලම් සොයා ගත් බව ය. කොට්ට උරයේ වර්ග අඟලක බැක්ටීරියා මිලියන තුනකට ආසන්න ප්රමාණයක් අඩංගු වූ බව එනම්, සාමාන්ය වැසිකිළි ආසනයක මෙන් 17,000 ගුණයකට ආසන්න ය.
මේ අතර, 2006 දී ඩෙනින් සහ සගයෝ මිතුරන්ගෙන් සහ පවුලෙන් කොට්ට 6ක් එකතු කර ගත්හ. එම කොට්ට මාස 18ක් හෝ 20 අතර කාලයේ දිගට ම පාවිච්චි කළ ඒවා විය. පසෙන් බහුලව හමු වන වර්ගයක් වන Aspergillus fumigatus දිලීර විශේෂය සියලු කොට්ටවල තිබී හමු විය.
ඡායාරූප මූලාශ්රය, Getty Images
"සංඛ්යාත්මකව නම් මේ කතා කරන්නේ හැම කොට්ටයක ම තියෙන බිලියන හෝ ට්රිලියන ගණනක දිලීර අංශු ගැන," ඩෙනින් පවසයි.
"අපි හිතනවා ඇයි අපට ගොඩක් [දිලීර] හමුවෙන්නේ කියලා, මොක ද බහුතරයක් අපිට රෑට අපේ ඔළුවලින් දහදිය දානවා. අපි හැමෝගෙම ඇඳන්වල දූවිලි මයිටාවන්ගේ ගෙවල් තියෙනවා සහ දූවිලි මයිටාවන්ගේ මලපහ දිලීරවලට ජීවත් වෙන්න ආහාරත් සපයනවා. ඒ වගේ ම එතකොට අපි ඔළුව තියාගෙන ඉන්න නිසා හැම හවසක ම අනිවාර්යයෙන් ම කොට්ටය උණුසුම් වෙනවා. තෙතමනය තියෙනවා, කෑම තියෙනවා, සහ උණුසුම තියෙනවා."
අපගෙන් බහුතරයක් කොට්ට සෝදන්නේ කලාතුරකින් වන නිසා දිලීර තරමක් සාමකාමී තත්ත්වයකින් පවතින අතර, වසර ගණනාවක් නොමැරී සිටිය හැකි ය. දිලීරවලට බාධා වන එක ම අවස්ථාව වන්නේ, අපගේ නිදන කාමරයට දිලීර බීජාණු නිකුත් විය හැකි අපේ කොට්ට ඇඳ ඇතිරිලි ගසා දමන විට ය. අපි ඒවා සේදුවත් සෙල්සියස් අංශක 50ක (122F) උෂ්ණත්වයක් දක්වා දිලීරවලට නොනැසී පැවතිය හැකි අතර කොට්ට සෝදන ඕනෑ ම අවස්ථාවක ඒවාට තවත් තෙතමනය ලැබී දිලීරවලට තවදුරටත් වර්ධනය වීමට ඉඩ ලබා දෙයි.
"ඇතිරිලි සේදීම සහ මැදීම මගින් ද ලිනන්වල බැක්ටීරියා සංඛ්යාව අඩු වෙයි"
මිනිසුන් නිදා ගැනීමට ගත කරන කාලය සහ කොට්ටයේ සිට මුඛයට ඇති සමීපත්වය නිසා මෙම සොයා ගැනීම, විශේෂයෙන් ම ඇදුම සහ සයිනසයිටිස් වැනි ශ්වසන ආබාධ ඇති රෝගීන්ට වැදගත් ඇඟවුමකි. උග්ර ක්ෂය රෝගය ඇති පුද්ගලයන්ගෙන් අඩකට වැඩි පිරිසක් Aspergillus fumigatus සඳහා ආසාත්මිකතාවක් දක්වන අතර, මීට පෙර ක්ෂය රෝගයෙන් හෝ දුම්පානයට සම්බන්ධ පෙනහලු රෝගවලින් පීඩා විඳි මිනිසුන් තුළ නිදන්ගත පෙනහලු රෝග ඇති විය හැකි ය. ඩෙනින්ට අනුව, සෞඛ්ය සම්පන්න ප්රතිශක්තිකරණ පද්ධතියක් ඇති පුද්ගලයන්ගෙන් 99.9%කට A. fumigatus දිලීර බීජාණු ආශ්වාස කිරීම සමග පහසුවෙන් මුහුණ දිය හැකි අතර, ප්රතිශක්තිකරණය අඩු පුද්ගලයන් තුළ දිලීරයට ධාරකයාගේ දුර්වල ආරක්ෂාව ඉක්මවා ගොස් ජීවිතයට තර්ජනයක් විය හැකි ආසාදනයකට හේතු විය හැකි ය.
"ඔබට ලියුකේමියාව තිබේ නම්, අවයවයක් බද්ධ කර තිබේ නම් හෝ, නැතිනම් කොවිඩ් හෝ ඉන්ෆ්ලුවෙන්සා සමඟ දැඩිසත්කාර ප්රතිකාර ලබා ගැනීමට අවාසනාවන්ත වූයේ නම්, දිලීර පෙනහලු තුළට ඇතුළු වී දිගට ම ගමන් කරමින් පෙනහලු පටක විනාශ කරන ආක්රමණශීලී Aspergillosis ලෙස හඳුන්වන [දිලීර ආසාදනය] ඔබට ඇති විය හැකි යි,"ඩෙනින් පවසයි.

ඡායාරූප මූලාශ්රය, Getty Images
කොට්ට සේදීමෙන් උපකාරයක් සිදු වන්නේ නැතිනම් අපට කළ හැකි වෙනත් දෙයක් තිබේ ද? ඩෙනින්ට අනුව ඔබට ඇදුම හෝ පෙනහලු රෝගයක් හෝ සයිනස් රෝගය නොමැති නම් ඔබ සෑම වසර දෙකකට වරක් ම ඔබේ කොට්ටය මාරු කිරීම ගැන සලකා බැලිය යුතු ය. නමුත් මෙම රෝගයන්ගෙන් පීඩා විඳින මිනිසුන් සෑම මාස තුනකට ම හෝ හයකට ම වරක් අලුතෙන් කොට්ටයක් මිලට ගත යුතු ය.
මේ අතර, ඇඳ ආවරණ කී වාරයක් ඔබ සේදිය යුතු ද යන ප්රශ්නයේදී බොහෝ විශේෂඥයන් නිර්දේශ කරන්නේ සතිපතා එය සිදු කරන ලෙස ය. ඇතිරිලි සේදීම මෙන් ම මැදීම ද ලිනන්වල බැක්ටීරියා සංඛ්යාව අඩු කරයි.
"ඔයාට වෙනත් යමක් කරන්න නැති නම් ඔයා පරිස්සමින් ඔයාගේ ඇතිරිලි අයන් කරන්න ඕනෑ. කොහොම වුණත් අපේ ශරීරයේ බැක්ටීරියා තියෙනවා ඒත් [ සෞඛ්ය සම්පන්න පුද්ගලයෙක්ට] ඒක ප්රශ්නයක් නෙවෙයි," ඩෙනින් පවසයි.
“නමුත් ඔයා අසනීප හෝ අවදානම්සහගත කෙනෙක් නම් ඒක වඩාත් වැදගත් වෙනවා. ඇඳ තෙමන දරුවෙක් ඔයාට ඉන්නවා නම් ඔයාට සේදීම සහ සේදීමට වැඩි උෂ්ණත්වයක් යොදා ගැනීම ගැන අනිවාර්යයෙන් ම වැඩිපුර ටිකක් පරිස්සම් වෙන්න සිදුවෙනවා.”
ඇඳේ සුරතල් සතෙකු නිදාගැනීම, ඇඳට යාමට පෙර ස්නානය නොකිරීම, අපිරිසිදු මේස් සමග ඇඳට යාම හෝ මේකප් හෝ ලෝෂන් ඔබේ සමේ තිබියදී නිදා ගැනීම ද බැක්ටීරියා සහ දිලීර සංඛ්යාව වැඩි කරන අතර, එය අප ඇඳේ සිට උදේ ආහාරයට හෝ මධ්යම රාත්රීයේ කැමක් ගැනීමට පෙර සලකා බැලිය යුතු ය.
"මම කියන්නේ නෑ කවුරුත් ඇඳේ ඉඳන් කෑම කන්න එපා කියලා, නමුත් මම හිතන්නේ ඔයා එහෙම කරනවා නම් නිතර ම ඇඳ ඇතිරිලි සේදීම වැදගත් කියලා. ඒ වගේ ම මම හිතනවා අවංක පිළිතුරක් වෙන්නේ සතිපතා [ඇතිරිලි සේදීම] එතරම් ප්රමාණවත් නෑ කියලා," ඩෙනින් පවසයි.














